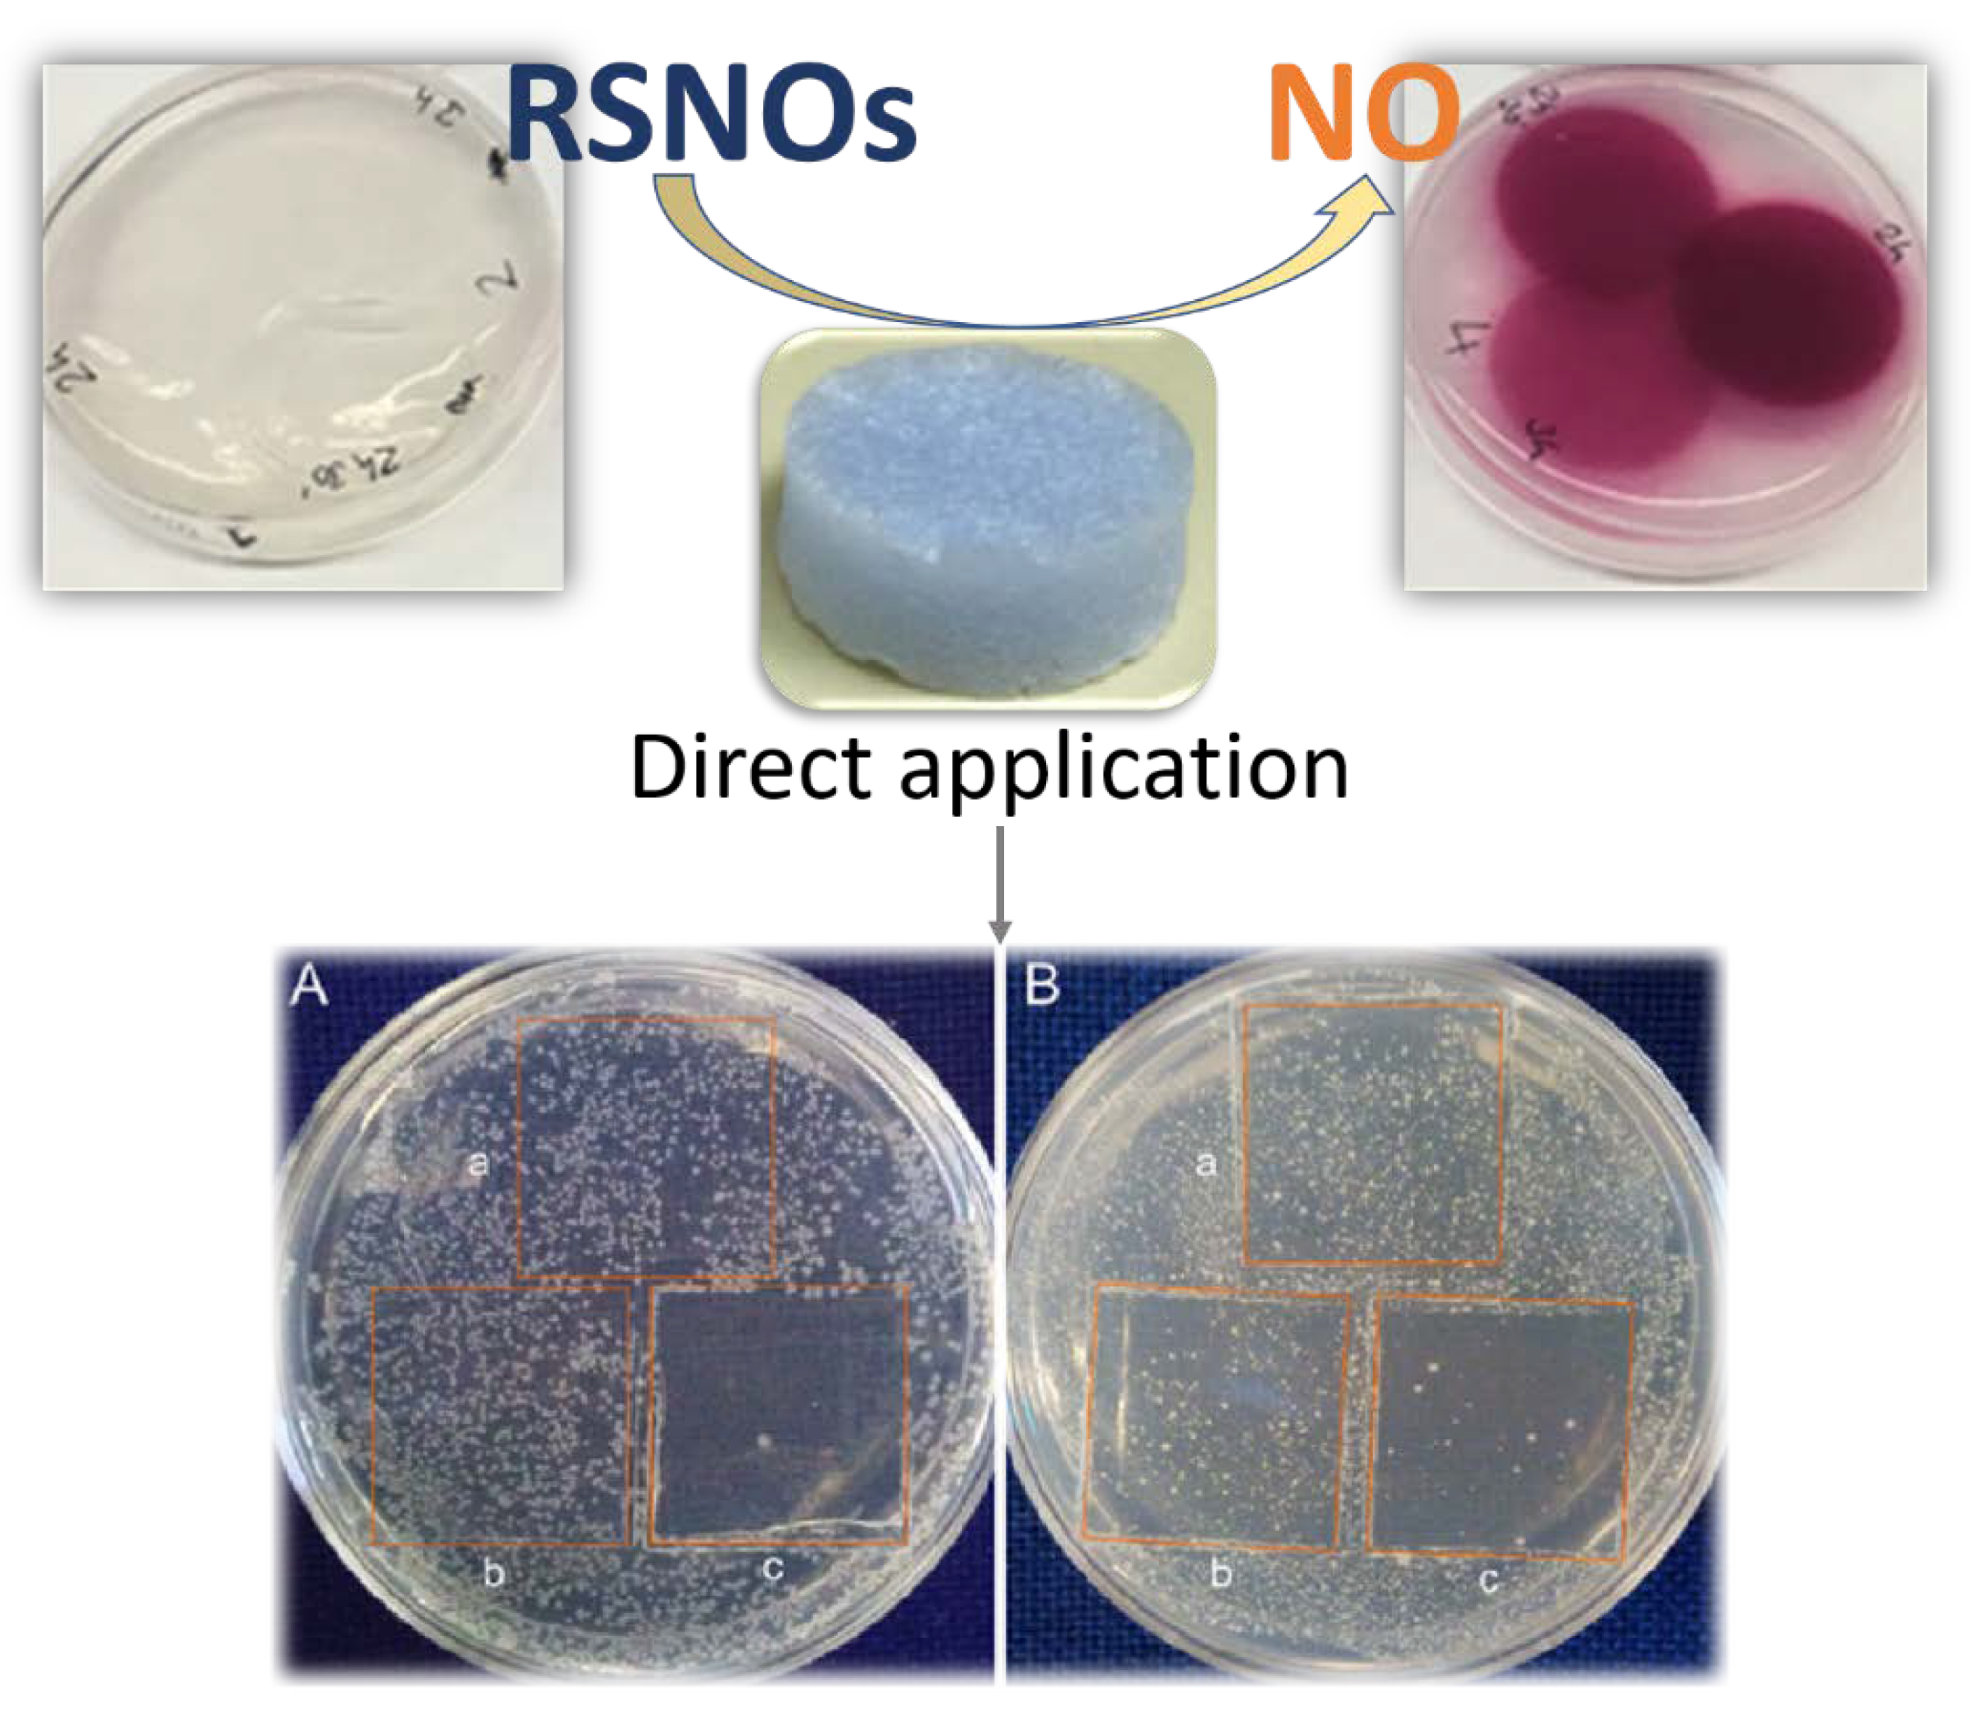
Nanomaterials 11 01865 g029

Advances and Novel Perspectives on Colloids, Hydrogels, and Aerogels Based on Coordination Bonds with Biological Interest Ligands
Abstract
:1. Introduction
- (i)
- According to the nature of solvents such as hydrogels or organogels.
- (ii)
- Depending upon the force driving their molecular aggregation. In this sense, the gel is classified as a physical or supramolecular gel when gelation is caused by intermolecular non-covalent interactions, such as hydrogen bonding, hydrophobic interactions, dipolar interactions, electrostatic interactions, and π–π stacking. In contrast, when covalent bonds drive the cross-linking, the gel is defined as a chemical gel.
- (iii)
- There are also gels depending on their composition, such as purely inorganic, which are mainly made up of metal nanoparticles and metal oxides. Inorganic and organic hybrids, where organic molecules are introduced to the aforementioned oxides. Purely organic, and finally, around 2004, new coordination compound gels and aerogels began to appear called metal–organic gels (MOGs), or coordination polymer gels (CPGs) [1].
2. Colloid Dispersions Based on Coordination Bonds with Interesting Biological Ligands
2.1. Nucleobases and Nucleotides for the Creation of Colloids Useful as Luminescent, Nanocarriers, Or 3D Printed Sensors
3. Hydrogels Based on Coordination Bonds with Bioinspired Ligands
3.1. Oligonucleotides, Nucleotides, and Nucleobases as Gelators for the Creation of Novel Stimuli–Response and Self-Healing Metal–Organic Hydrogels for Drug Delivery, Wastewater Treatment, Catalysis and Antibacterial Applications
3.2. Amino Acids and Peptides as Gelators for the Creation of Novel Stimuli–Response, Self-Healing, Catalytic and Antibacterial Metal–Organic Hydrogels
4. Aerogels Based on Coordination Bonds with Biological Interest Ligands
Amino Acids and Nucleobases as Building Blocks to Generate Novel Composite/Hybrid Metal–Organic Aerogels Useful for Energy and Bioanalytical Applications
5. Conclusions
Funding
Data Availability Statement
Conflicts of Interest
References
- Jung, J.H.; Lee, J.H.; Silverman, J.R.; John, G. Coordination polymer gels with important environmental and biological applications. Chem. Soc. Rev. 2013, 42, 924–936. [Google Scholar] [CrossRef]
- Sun, Z.; Li, X.; Qu, K.; Zhang, Z.; Niu, Y.; Xu, W.; Ren, C. A review on recent advances in gel adhesion and their potential applications. J. Mol. Liq. 2021, 325, 115254. [Google Scholar] [CrossRef]
- Estroff, L.A.; Hamilton, A.D. Calcite growth in hydrogels: Assessing the mechanism of polymer network incorporation into single crystals. Chem. Rev. 2004, 104, 1201–1218. [Google Scholar] [CrossRef]
- Terech, P.; Weiss, R.G. Molecular organogels. Soft matter comprised of low-molecular-mass organic gelators and organic liquids. Chem. Rev. 1997, 97, 3133–3160. [Google Scholar] [CrossRef] [PubMed]
- Haering, M.; Tautz, M.; Alegre-Requena, J.V.; Saldias, C.; Diaz, D.D. Non-enzyme entrapping biohydrogels in catalysis. Tetrahedron Lett. 2018, 59, 3293–3306. [Google Scholar] [CrossRef]
- Maleki, H.; Duraes, L.; García-González, C.A.; del Gaudio, P.; Portugal, A.; Mahmoudi, M. Synthesis and biomedical applications of aerogels: Possibilities and challenges. Adv. Colloid Interfac. Sci. 2016, 236, 1–27. [Google Scholar] [CrossRef]
- Pierre, A.C.; Pajonk, G.M. Chemistry of aerogels and their applications. Chem. Rev. 2002, 102, 4243–4266. [Google Scholar] [CrossRef]
- Sutar, P.; Maji, T.K. Recent advances in coordination-driven polymeric gel materials: Design and applications. Dalton Trans. 2020, 49, 7658–7672. [Google Scholar] [CrossRef]
- Wang, L.; Xu, H.; Gao, J.; Yao, J.; Zhang, Q. Recent progress in metal-organic frameworks-based hydrogels and aerogels and their applications. Coord. Chem. Rev. 2019, 398, 213016. [Google Scholar] [CrossRef]
- Lopez, A.; Liu, J. Self-assembly of nucleobase, nucleoside and nucleotide coordination polymers: From synthesis to applications. ChemNanoMat 2017, 3, 670–684. [Google Scholar] [CrossRef]
- Karan, C.K.; Bhattacharjee, M. A Copper Metal–Organic Hydrogel as a Catalyst for SO2 and CO2 Fixation under Ambient Conditions. Eur. J. Inorg. Chem. 2019, 3605–3611. [Google Scholar] [CrossRef]
- Bera, S.; Chakraborty, A.; Karak, S.; Halder, A.; Chatterjee, S.; Saha, S.; Banerjee, R. Multistimuli-responsive interconvertible low-molecular weight metallohydrogels and the in situ entrapment of CdS quantum dots therein. Chem. Mater. 2018, 30, 4755–4761. [Google Scholar] [CrossRef]
- Sharma, B.; Mahata, A.; Mandani, S.; Thakur, N.; Pathak, B.; Sarma, T.K. Zn (ii)–nucleobase metal–organic nanofibers and nanoflowers: Synthesis and photocatalytic application. New J. Chem. 2018, 42, 17983–17990. [Google Scholar] [CrossRef]
- Bauri, K.; Nandi, M.; De, P. Amino acid-derived stimuli-responsive polymers and their applications. Polym. Chem. 2018, 9, 1257–1287. [Google Scholar] [CrossRef]
- Maldonado, N.; Amo-Ochoa, P. The role of coordination compounds in virus research. Different approaches and trends. Dalton Trans. 2021, 50, 2310. [Google Scholar] [CrossRef] [PubMed]
- Maldonado, N.; Amo-Ochoa, P. New promises and opportunities in 3D printable inks based on coordination compounds for the creation of objects with multiple applications. Chem. Eur. J. 2020, 26, 1–22. [Google Scholar] [CrossRef] [PubMed]
- Maldonado, N.; Vegas, V.G.; Halevi, O.; Martínez, J.I.; Lee, P.S.; Magdassi, S.; Wharmby, M.T.; Platero-Prats, A.E.; Moreno, C.; Zamora, F.; et al. 3D Printing of a Thermo-and Solvatochromic Composite Material Based on a Cu (II)–Thymine Coordination Polymer with Moisture Sensing Capabilities. Adv. Funct. Mater. 2019, 29, 1808424. [Google Scholar] [CrossRef]
- Vegas, V.G.; Lorca, R.; Latorre, A.; Hassanein, K.; Gómez-García, C.J.; Castillo, O.; Somoza, Á.; Zamora, F.; Amo-Ochoa, P. Copper (II)–Thymine Coordination Polymer Nanoribbons as Potential Oligonucleotide Nanocarriers. Angew. Chem. Int. Ed. 2017, 56, 987–991. [Google Scholar] [CrossRef]
- Roucoux, A.; Schulz, J.; Patin, H. Reduced transition metal colloids: A novel family of reusable catalysts? Chem. Rev. 2002, 102, 3757–3778. [Google Scholar] [CrossRef] [PubMed]
- Saunders, B.R.; Vincent, B. Microgel Particles as Model Colloids: Theory, Properties and Applications. Adv. Colloid Interface Sci. 1999, 80, 1–25. [Google Scholar] [CrossRef]
- Ebbens, S.J. Active colloids: Progress and challenges towards realising autonomous applications. Curr. Opin. Colloid Interface Sci. 2016, 21, 14–23. [Google Scholar] [CrossRef] [Green Version]
- Nuthanakanti, A.; Srivatsan, S.G. Surface-tuned and metal-ion-responsive supramolecular gels based on nucleolipids. ACS Appl. Mater. Interfaces 2017, 9, 22864–22874. [Google Scholar] [CrossRef]
- Wu, H.; Zheng, J.; Kjøniksen, A.-L.; Wang, W.; Zhang, Y.; Ma, J. Metallogels: Availability, applicability, and advanceability. Adv. Mater. 2019, 31, 1806204. [Google Scholar] [CrossRef]
- Dash, J.; Patil, A.J.; Das, R.N.; Dowdall, F.L.; Mann, S. Supramolecular hydrogels derived from silver ion-mediated self-assembly of 5′-guanosine monophosphate. Soft Matter 2011, 7, 8120–8126. [Google Scholar] [CrossRef]
- Xu, L.; Zhang, Z.; Fang, X.; Liu, Y.; Liu, B.; Liu, J. Robust hydrogels from lanthanide nucleotide coordination with evolving nanostructures for a highly stable protein encapsulation. ACS Appl. Mater. Interfaces 2018, 10, 14321–14330. [Google Scholar] [CrossRef] [PubMed]
- Wang, R.; Geiger, C.; Chen, L.; Swanson, B.; Whitten, D.G. Direct Observation of Sol−Gel Conversion: The Role of the Solvent in Organogel Formation. J. Am. Chem. Soc. 2000, 122, 2399–2400. [Google Scholar] [CrossRef]
- Qiu, H.; Pu, F.; Liu, Z.; Liu, X.; Dong, K.; Liu, C.; Ren, J.; Qu, X. Hydrogel-based artificial enzyme for combating bacteria and accelerating wound healing. Nano Res. 2020, 13, 496–502. [Google Scholar] [CrossRef]
- Thombare, N.; Mishra, S.; Siddiqui, M.Z.; Jha, U.; Singh, D.; Mahajan, G.R. PT effect on water retention capacity of soil SC. Carbohy. Polym. 2018, 185, 169–178. [Google Scholar] [CrossRef] [PubMed]
- Curvello, R.; Raghuwanshi, V.S.; Garnier, G. Engineering nanocellulose hydrogels for biomedical applications. Adv. Colloid Interfac. Sci. 2019, 267, 47–61. [Google Scholar] [CrossRef] [PubMed]
- Mu, M.; Li, X.; Tong, A.; Guo, G. Multi-functional chitosan-based smart hydrogels mediated biomedical application. Expert Opin. Drug Deliv. 2019, 16, 239–250. [Google Scholar] [CrossRef]
- Reyes-Martinez, J.E.; Ruiz-Pacheco, J.A.; Flores-Valdez, M.A.; Elsawy, M.A.; Vallejo-Cardona, A.A.; Castillo-Diaz, L.A.J. Advanced hydrogels for treatment of diabetes. Tissue Eng. Regen. Med. 2019, 13, 1375–1393. [Google Scholar] [CrossRef] [PubMed]
- Zhang, J.; Su, C.-Y. Metal-organic gels: From discrete metallogelators to coordination polymers. Coord. Chem. Rev. 2013, 257, 1373–1408. [Google Scholar] [CrossRef]
- Pu, F.; Ren, J.; Qu, X. Nucleobases, nucleosides, and nucleotides: Versatile biomolecules for generating functional nanomaterials. Chem. Soc. Rev. 2018, 47, 1285–1306. [Google Scholar] [CrossRef] [PubMed]
- Das, R.N.; Kumar, Y.P.; Pagoti, S.; Patil, A.J.; Dash, J. Diffusion and birefringence of bioactive dyes in a guanosine supramolecular hydrogel. Chem. A Eur. J. 2012, 18, 6008–6014. [Google Scholar] [CrossRef] [PubMed]
- Liang, H.; Zhang, Z.; Yuan, Q.; Liu, J. Self-healing metal-coordinated hydrogels using nucleotide ligands. Chem. Commun. 2015, 51, 15196–15199. [Google Scholar] [CrossRef] [PubMed] [Green Version]
- Kumar, A.; Gupta, S.K. Supramolecular-directed novel superparamagnetic 5′-adenosine monophosphate templated β-FeOOH hydrogel with enhanced multi-functional properties. Green Chem. 2015, 17, 2524. [Google Scholar] [CrossRef]
- Sharma, B.; Mahata, A.; Mandani, S.; Sarma, T.K.; Pathak, B. Coordination polymer hydrogels through Ag (I)-mediated spontaneous self-assembly of unsubstituted nucleobases and their antimicrobial activity. RSC Adv. 2016, 6, 62968–62973. [Google Scholar] [CrossRef]
- Thakur, N.; Sharma, B.; Bishnoi, S.; Mishra, S.K.; Nayak, D.; Kumar, A.; Sarma, T.K. Multifunctional inosine monophosphate coordinated metal–organic hydrogel: Multistimuli responsiveness, self-healing properties, and separation of water from organic solvents. ACS Sustain. Chem. Eng. 2018, 6, 8659–8671. [Google Scholar] [CrossRef]
- Sharma, B.; Mandani, S.; Thakur, N.; Sarma, T.K. Cd (ii)–nucleobase supramolecular metallo-hydrogels for in situ growth of color tunable CdS quantum dots. Soft Matter 2018, 14, 5715–5720. [Google Scholar] [CrossRef]
- Wegner, K.D.; Hildebrandt, N. Quantum dots: Bright and versatile in vitro and in vivo fluorescence imaging biosensors. Chem. Soc. Rev. 2015, 44, 4792–4834. [Google Scholar] [CrossRef] [Green Version]
- Zrazhevskiy, P.; Sena, M.; Gao, X. Designing multifunctional quantum dots for bioimaging, detection, and drug delivery. Chem. Soc. Rev. 2010, 39, 4326–4354. [Google Scholar] [CrossRef] [Green Version]
- Lesnyak, V.; Gaponik, N.; Eychmüller, A. Colloidal semiconductor nanocrystals: The aqueous approach. Chem. Soc. Rev. 2013, 42, 2905–2929. [Google Scholar] [CrossRef]
- Chen, W.-H.; Liao, W.-C.; Sohn, Y.S.; Fadeev, M.; Cecconello, A.; Nechushtai, R.; Willner, I. Stimuli-responsive nucleic acid-based polyacrylamide hydrogel-coated metal–organic framework nanoparticles for controlled drug release. Adv. Funct. Mater. 2018, 28, 1705137. [Google Scholar] [CrossRef]
- Li, C.-H.; Wang, C.; Keplinger, C.; Zuo, J.-L.; Jin, L.; Sun, Y.; Zheng, P.; Cao, Y.; Lissel, F.; Linder, C.; et al. A highly stretchable autonomous self-healing elastomer. Nat. Chem. 2016, 8, 618–624. [Google Scholar] [CrossRef]
- Basak, S.; Nanda, J.; Banerjee, A. Multi-stimuli responsive self-healing metallo-hydrogels: Tuning of the gel recovery property. Chem. Commun. 2014, 50, 2356–2359. [Google Scholar] [CrossRef] [PubMed]
- Ray, S.; Das, A.K.; Banerjee, A. pH-Responsive, Bolaamphiphile-Based Smart Metallo-Hydrogels as Potential Dye-Adsorbing Agents, Water Purifier, and Vitamin B12 Carrier. Chem. Mater. 2007, 19, 1633–1639. [Google Scholar] [CrossRef]
- Singh, R.; Mishra, K.N.; Kumar, V.; Vinayak, V.; Joshi, K.B. Transition Metal Ion–Mediated Tyrosine-Based Short-Peptide Amphiphile Nanostructures Inhibit Bacterial Growth. ChemBioChem 2018, 19, 1630–1637. [Google Scholar] [CrossRef]
- Maity, I.; Rasale, D.B.; Das, A.K. Sonication induced peptide-appended bolaamphiphile hydrogels for in situ generation and catalytic activity of Pt nanoparticles. Soft Matter 2012, 8, 5301–5308. [Google Scholar] [CrossRef]
- Liu, Y.; Wang, T.; Li, Z.; Liu, M. Copper(ii) ion selective and strong acid-tolerable hydrogels formed by an l-histidine ester terminated bolaamphiphile: From single molecular thick nanofibers to single-wall nanotubes. Chem. Commun. 2013, 49, 4767–4769. [Google Scholar] [CrossRef] [PubMed]
- Leong, W.L.; Tam, A.Y.-Y.; Batabyal, S.K.; Koh, L.W.; Kasapis, S.; Yam, V.W.-W.; Vittal, J.J. Fluorescence enhancement of coordination polymeric gel. Chem. Commun. 2008, 31, 3628–3630. [Google Scholar] [CrossRef] [PubMed]
- Malkin, A.Y.; Isayev, A.I. Rheology: Concepts, Methods and Applications. In Applied Rehology; ChemTec Publishing: Toronto, ON, Canada, 2006; Volume 16. [Google Scholar] [CrossRef]
- Leong, W.L.; Batabyal, S.K.; Kasapis, S.; Vittal, J.J. Fluorescent Magnesium(II) Coordination Polymeric Hydrogel. Chem. A Eur. J. 2008, 14, 8822–8829. [Google Scholar] [CrossRef]
- Wang, X.; He, T.; Yang, L.; Wu, H.; Zhang, R.; Zhang, Z.; Shen, R.; Xiang, J.; Zhang, Y.; Wei, C. A Co2+-selective and chirality-sensitive supermolecular metallohydrogel with a nanofiber network skeleton. Nanoscale 2016, 8, 6479–6483. [Google Scholar] [CrossRef]
- Wang, X.; He, T.; Yang, L.; Wu, H.; Yin, J.; Shen, R.; Xiang, J.; Zhang, Y.; Wei, C. Designing isometrical gel precursors to identify the gelation pathway for nickel-selective metallohydrogels. Dalton Trans. 2016, 45, 18438–18442. [Google Scholar] [CrossRef]
- Wang, X.; Wei, C.; He, T.; Yang, L.; Wu, H.; Yin, J.; Shen, R.; Xiang, J.; Zhang, Y. Pb2+-specific metallohydrogel based on tryptophan-derivatives: Preparation, characterization, multi-stimuli responsiveness and potential applications in wastewater and soil treatment. RSC Adv. 2016, 6, 81341–81345. [Google Scholar] [CrossRef]
- Wei, C.; Wang, X.; Gao, S.; Wen, G.; Lin, Y.W. A La3+-selective metallohydrogel with a facile gelator of a phenylalanine derivative containing an imidazole group. Dalton Trans. 2018, 47, 13788–13791. [Google Scholar] [CrossRef] [PubMed]
- Sasikala, V.; Mani, R.; Vignesh, S.; Sundara, J.K. Multifunctional properties of bio-supramolecular gel with their structural transformation and its applications. Colloids Surf. A 2019, 583, 123993. [Google Scholar] [CrossRef]
- Ahmad, S.; Yousaf, A.; Tahir, M.N.; Isab, A.A.; Monim-ul-Mehboob, M.; Linert, W.; Saleem, M. Structural characterization and antimicrobial activity of a silver (I) complex of arginine. J. Struct. Chem. 2015, 56, 1653–1657. [Google Scholar] [CrossRef]
- Li, J.; Li, W.; Xia, D.; Xiang, C.; Chen, Y.; Li, G. Dynamic coordination of natural amino acids-lanthanides to control reversible luminescent switching of hybrid hydrogels and anti-counterfeiting. Dyes Pigm. 2019, 166, 375–380. [Google Scholar] [CrossRef]
- Liu, Y.; Ma, W.; Liu, W.; Li, C.; Liu, Y.; Jiang, X.; Tang, Z.J. Silver (I)–glutathione biocoordination polymer hydrogel: Effective antibacterial activity and improved cytocompatibility. Mater. Chem. 2011, 21, 19214–19218. [Google Scholar] [CrossRef]
- Hu, Y.; Xu, W.; Li, G.; Xu, L.; Song, A.; Hao, J. Self-assembled peptide nanofibers encapsulated with superfine silver nanoparticles via Ag+ coordination. Langmuir 2015, 31, 8599–8605. [Google Scholar] [CrossRef] [PubMed]
- Guo, Y.; Wang, S.; Du, H.; Chen, X.; Fei, H. Silver ion-histidine interplay switches peptide hydrogel from antiparallel to parallel β-Assembly and enables controlled antibacterial activity. Biomacromolecules 2019, 20, 558–565. [Google Scholar] [CrossRef]
- Song, J.; Yuan, C.; Jiao, T.; Xing, R.; Yang, M.; Adamas, D.J.; Yan, X. Multifunctional antimicrobial biometallohydrogels based on amino acid coordinated self-assembly. Small 2020, 16, 1907309. [Google Scholar] [CrossRef] [PubMed]
- Pu, F.; Liu, X.; Xu, B.; Ren, J.; Qu, X. Rapid magnetic solid-phase extraction of Congo Red and Basic Red 2 from aqueous solution by ZIF-8@ CoFe2O4 hybrid composites. Chem. Eur. J. 2012, 18, 4322–4328. [Google Scholar] [CrossRef] [PubMed]
- Wu, H.; Tian, C.; Zhang, Y.; Xang, C.; Zhang, S.; Jiang, Z. Stereoselective assembly of amino acid-based metal–biomolecule nanofibers. Chem. Commun. 2015, 51, 6329–6332. [Google Scholar] [CrossRef] [PubMed]
- Imaz, I.; Rubio-Martínez, M.; Saletra, W.J.; Amabilino, D.B.; Maspoch, D. Amino acid based metal− organic nanofibers. J. Am. Chem. Soc. 2009, 131, 18222–18223. [Google Scholar] [CrossRef] [PubMed]
- Xu, C.; Cai, Y.; Ren, C.; Gao, J.; Hao, J. Zinc-triggered hydrogelation of self-assembled small molecules to inhibit bacterial growth. Sci. Rep. 2015, 5, 7753. [Google Scholar] [CrossRef] [Green Version]
- Zeng, L.; Song, M.; Gu, J.; Xu, Z.; Xue, B.; Li, Y.; Cao, Y. A highly stretchable, tough, fast self-healing hydrogel based on peptide–metal ion coordination. Biomimetics 2019, 4, 36. [Google Scholar] [CrossRef] [PubMed] [Green Version]
- Li, L.; Li, B.; Zhang, J. Dopamine-mediated fabrication of ultralight graphene aerogels with low volume shrinkage. J. Mater. Chem. A 2016, 4, 512–518. [Google Scholar] [CrossRef]
- Inonu, Z.; Keskin, S.; Erkey, C. An emerging family of hybrid nanomaterials: Metal–organic framework/aerogel composites. ACS Appl. Nano Mater. 2018, 1, 5959–5980. [Google Scholar] [CrossRef]
- Lee, Y.A.; Lee, J.; Kim, D.W.; Yoo, C.-Y.; Park, S.H.; Yoo, J.J.; Kim, S.; Kim, B.; Cho, W.K.; Yoon, H. Mussel-inspired surface functionalization of porous carbon nanosheets using polydopamine and Fe3+/tannic acid layers for high-performance electrochemical capacitors. J. Mater. Chem. A 2017, 5, 25368–25377. [Google Scholar] [CrossRef]
- Worsley, M.A.; Pauzauskie, P.J.; Olson, T.Y.; Biener, J.; Satcher, J.H.; Baumann, T.F. Synthesis of graphene aerogel with high electrical conductivity. J. Am. Chem. Soc. 2010, 132, 14067–14069. [Google Scholar] [CrossRef] [PubMed]
- Ha, H.; Shanmuganathan, K.; Ellison, C.J. Mechanically stable thermally crosslinked poly (acrylic acid)/reduced graphene oxide aerogels. ACS Appl. Mater. Interfaces 2015, 7, 6220–6229. [Google Scholar] [CrossRef] [PubMed]
- Wang, B.; Kang, Y.; Shen, T.-Z.; Song, J.-K.; Park, H.S.; Kim, J.-H. Ultralight and compressible mussel-inspired dopamine-conjugated poly (aspartic acid)/Fe3+-multifunctionalized graphene aerogel. J. Mater. Sci. 2018, 53, 16484–16499. [Google Scholar] [CrossRef]
- Darder, M.; Karan, A.; Real, G.D.; DeCoster, M.A. Cellulose-based biomaterials integrated with copper-cystine hybrid structures as catalysts for nitric oxide generation. Mater. Sci. Eng. C 2020, 108, 110369. [Google Scholar] [CrossRef]
- Vegas, V.G.; Beobide, G.; Castillo, O.; Reyes, E.; Gómez-García, C.J.; Zamora, F.; Amo-Ochoa, P. A bioinspired metal–organic approach to cross-linked functional 3D nanofibrous hydro-and aero-gels with effective mixture separation of nucleobases by molecular recognition. Nanoscale 2020, 12, 14699. [Google Scholar] [CrossRef] [PubMed]

| CPGs/MOGs | Range of Frequency | Constant Oscillation Strain (%) | Approx. Loss Moduli, G″ (Pa) | Approx. Storage Moduli, G′ (Pa) | References |
|---|---|---|---|---|---|
| Zn(II)-AMP | 0.03–30 Hz | 0.4 | 104 | 105 | [35] |
| Dy(III)-AMP | 0.1–100 Hz | 0.2 | 104 | 105 | [25] |
| Ag(I)- inosine 5′monophsphate (IMP) | 0.05–100 rad/s | 1 | ~10 | >55 | [38] |
| Ag(I)-A | 0.1–100 s−1 | 1 | 3 × 102 | 103 | [37] |
| Cd(II)–T | 0.05–100 rad/s | 1 | 25 | 100 | [39] |
| Cd(II)–U | 15 | 80 | |||
| Zn(II)–cytosine | 0.05–100 rad/s | 1 | 3 | 20 | [13] |
| Zn(II)–guanine | 1.5 | 10 |
| CPGs/MOGs | Range of Frequency | Constant Oscillation Strain (%) | Approx. Loss Moduli, G″ (Pa) | Approx. Storage Moduli, G′ (Pa) | References | |
|---|---|---|---|---|---|---|
| Ni(II)-derived tyrosine | P1 | 1–100 rad/s | 0.1 | 35 | 200 | [47] |
| P2 | 103 | 3 × 103 | ||||
| P3 | 2 × 103 | 0.5 × 104 | ||||
| Pt(II) nanoparticles-peptide(Phe) bolamphiphile | 0.01–100 Hz | - | 2 × 104 | 1.7 × 105 | [48] | |
| Pt(II) nanoparticles-peptide(Tyr) bolamphiphile | 3 × 104 | 1.5 × 105 | ||||
| Zn(II)-H2mugly | 0.1–10 rad/s | 0.5 | 13 | 23 | [50] | |
| Mg(II)-alanine derivative | 0.1–100 rad/s | 0.1 | 25 | 30 | [52] | |
| Cu(II)-amino succinic acid derivative (Cu-MOG) | 1–100 rad/s | 0.5 | 20 | 100 | [11] | |
| Co(II)-BTC-Arginine | 104 | 1 | [57] | |||
| Ag(I)-Fmoc-GCE | 0.1–10 Hz | - | <2 × 104 | >2 × 104 | [61] | |
| Ag(I)-IH6 | 0.1–100 rad/s | 0.1 | - | 4 × 104 | [62] | |
| Ag(I)-Fmoc-amino acids | 1–100 rad/s | 1 | 50–100 | 200–1000 | [63] | |
| Zn(II)-GGH | 0.01–100 rad/s | 0.1 | 103 | 103 | [68] | |
| Zn(II)-GHHPH | 0.01–100 rad/s | 0.1 | 550 | 103 | ||
| MOAs | Specific Surface Area (m2 g−1) | Pore Size (μm) | Density (mg cm−3) | Simplicity of the Synthesis | Application | References |
|---|---|---|---|---|---|---|
| polyaspartic acid + dopamine, PAAD-graphene oxide, rGO-Fe | 83.65 | 0.01–0.2 | 18.6 | complex | Supercapacitors | [74] |
| Cu-cysteine/cellulose | - | 4–130 | 41 | complex | Nitric oxide delivery | [75] |
| Cu-modified Uracil | 21 | 0.05–0.2 | 32.9 | simple | Stationary phase in HPLC | [76] |
| Metal Center | Biological Interest Ligands | Material State | Applications | References | |
|---|---|---|---|---|---|
| Nucleotides/nucleobases derivatives | Aminoacids/Peptides derivatives | ||||
| Ag(I) | GMP | Gel | Immobilization of protein | [24] | |
| A, C | Gel | Antibacterial | [37] | ||
| IMP | Gel | Antibacterial, catalyst and water treatment | [38] | ||
| Fmoc-GCE-OH | Gel | Sol-gel stimulus-response, catalyst and antibacterial | [61] | ||
| IH6 | Gel | Selective killing of wound-gressing/antibacterial | [62] | ||
| Fmoc-Amino acids | Gel | Drug-delivery/antibacterial | [63] | ||
| Ln(III) | AMP | Gel | Sol-gel stimulus-response and encapsulation of glucose oxidase enzyme. | [25] | |
| Cu(II) | TAcOH | Colloid | 3D printing ink and humidity sensor | [17,18] | |
| Aspartic acid | Gel | Catalyst, antibacterial, wound-healing agent | [25,66] | ||
| UAcOH | Aerogel | Stationary phase for HPLC column | [76] | ||
| Phenylalanine based-amphiphiles | Gel | Encapsulation of dyes and vitamin B12 molecules | [49] | ||
| Zn(II) | AMP | Gel | Sol-gel stimulus-response and self-healing | [35] | |
| GFFYGGGHGRGD | Gel | Antimicrobial | [67] | ||
| Cd(II) | T, U | Gel | Template for the in-situ quantum dots growth | [39] | |
| UiO-68 | ATP | Gel | Controlled drug release | [43] | |
| Ni(II) | Tyrosine-based amphiphiles | Gel | Sol-gel stimulus-response | [47] | |
| Mn(II), Co(II), Ni(II) | Phenylalanine based-amphiphiles | Gel | Encapsulation of dyes and vitamin B12 molecules | [46] | |
| Co(II) | BTC-arginine | Gel | Antibacterial/Sensor | [57] | |
| Mg(II) | N-(7-hydroxyl-4-methyl-8-coumarinyl)-alanine | Gel | pH and mechano-responsive | [52] | |
| Tb(III), Eu(III) | Phenylalanine | Gel | Luminescent inks for anti-counterfeiting | [59] | |
| Fe(III)/Fe(II) | Polyaspartic acid | Aerogel | Supercapacitors | [74] | |
| AMP | Gel | Superparamgnetic/porosity | [36] | ||
Publisher’s Note: MDPI stays neutral with regard to jurisdictional claims in published maps and institutional affiliations. |
© 2021 by the authors. Licensee MDPI, Basel, Switzerland. This article is an open access article distributed under the terms and conditions of the Creative Commons Attribution (CC BY) license (https://creativecommons.org/licenses/by/4.0/).
Share and Cite
Maldonado, N.; Amo-Ochoa, P. Advances and Novel Perspectives on Colloids, Hydrogels, and Aerogels Based on Coordination Bonds with Biological Interest Ligands. Nanomaterials 2021, 11, 1865. https://doi.org/10.3390/nano11071865
Maldonado N, Amo-Ochoa P. Advances and Novel Perspectives on Colloids, Hydrogels, and Aerogels Based on Coordination Bonds with Biological Interest Ligands. Nanomaterials. 2021; 11(7):1865. https://doi.org/10.3390/nano11071865
Chicago/Turabian StyleMaldonado, Noelia, and Pilar Amo-Ochoa. 2021. "Advances and Novel Perspectives on Colloids, Hydrogels, and Aerogels Based on Coordination Bonds with Biological Interest Ligands" Nanomaterials 11, no. 7: 1865. https://doi.org/10.3390/nano11071865
APA StyleMaldonado, N., & Amo-Ochoa, P. (2021). Advances and Novel Perspectives on Colloids, Hydrogels, and Aerogels Based on Coordination Bonds with Biological Interest Ligands. Nanomaterials, 11(7), 1865. https://doi.org/10.3390/nano11071865

